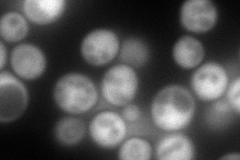
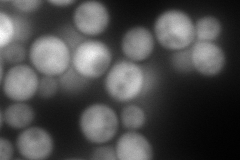
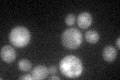

View description
Proteasome-interacting protein involved in the assembly of the base subcomplex of the 19S proteasomal regulatory particle (RP); ortholog of human oncoprotein gankyrin, which interacts with the Rb tumor suppressor and CDK4/6
Localization:
Intensity:
Fold change:
Significance:
-
C’ GFP library in SD

cytosol28.81 -
N' NOP1pr-GFP in SD
cytosol236.918 -
N' TEF2pr-mCherry in SD
cytosol327.632 -
N' NATIVEpr-GFP in SD

punctate,nucleus27.6266 -
N' TEF2pr-VC and Cyto-VN in SD

cytosol81.7251 -
C’ GFP library in SD+DTT

cytosol40.081.39Yes -
C’ GFP library in SD+H2O2

cytosol21.530.74No -
C’ GFP library in Starvation Media
cytosol46.521.61No -
C’ GFP library on the background of Pup2-DaMP

N/A -
C’ GFP library on the background of CCT mutant

N/A0N/AYes
